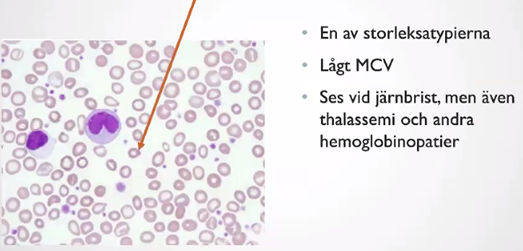
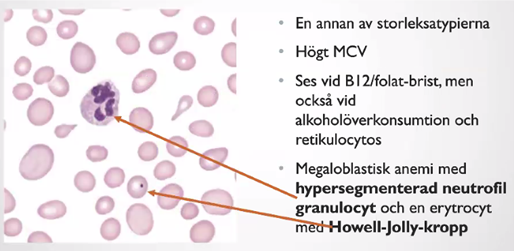
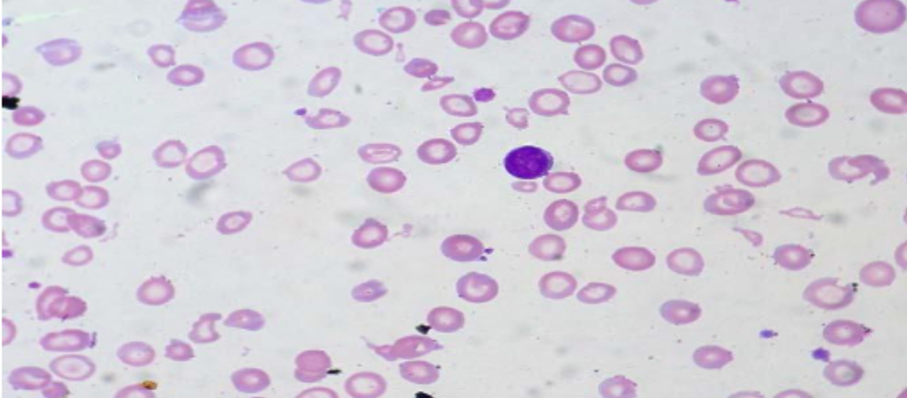
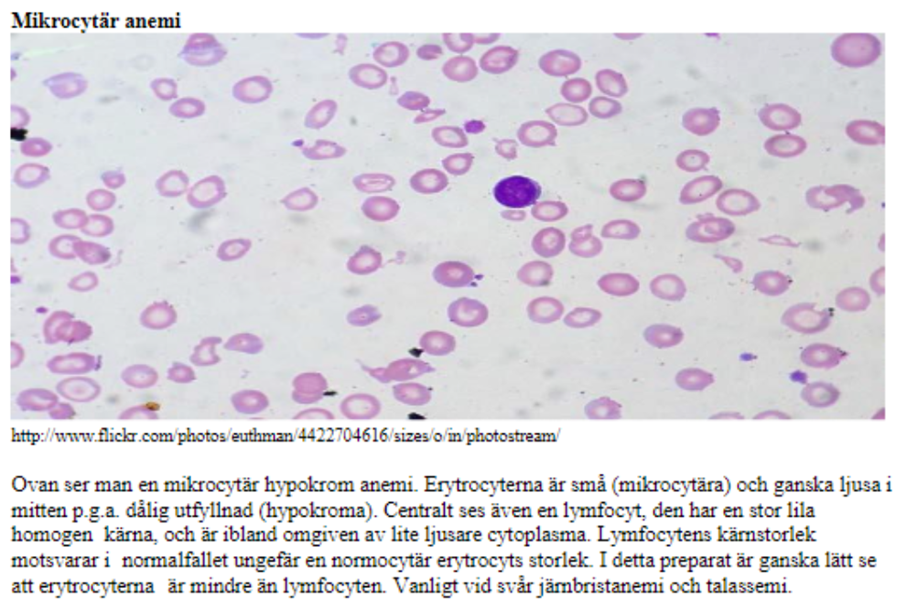
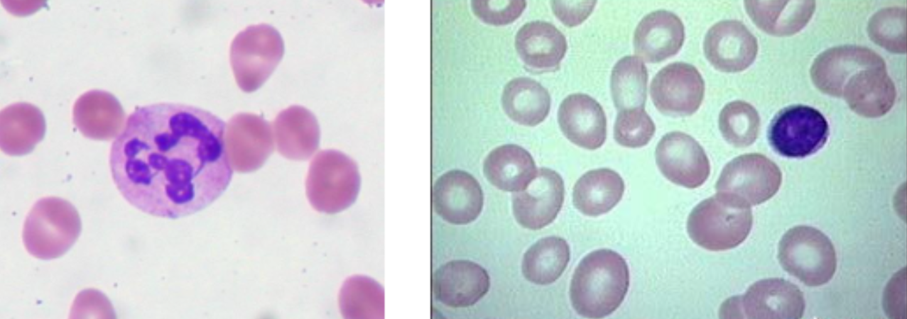
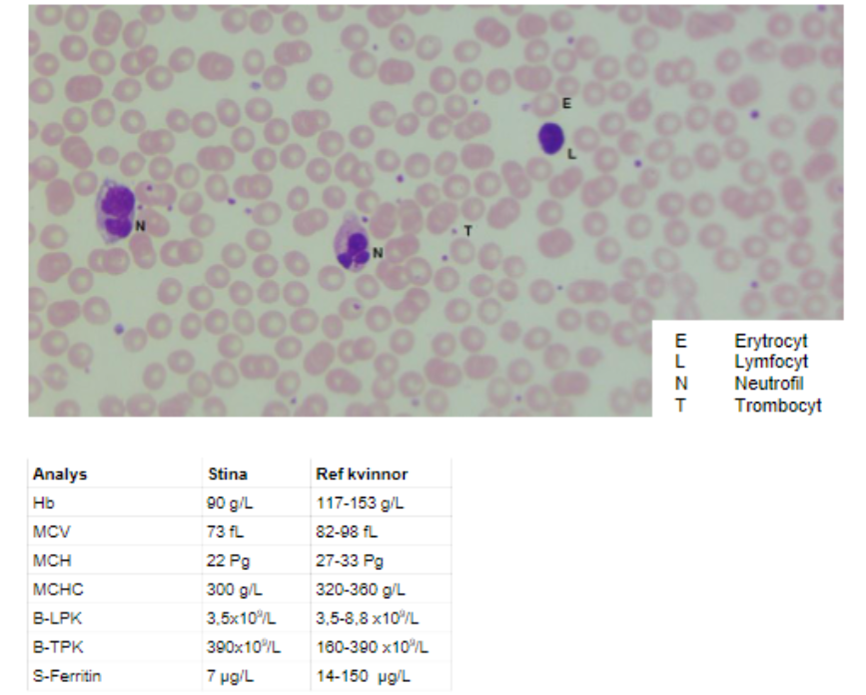

Vad är serum?
Plasma utan koagulationsfaktorer

Utveckling erytrocyt
Vad kallas den omogna erytrocyten som kan finnas i blodomloppet?
Hur länge finns erytrocyten i blodomloppet?

Vad innebär måttet/provet RDW?

Vad innebär EPK?
Erytrocytplasmakoncentration/liter
Vad innebär EVF?
Erytocytvolymfraktion
Vad innebär MCV?
Mean Cell Volume
EVF/EPK x 1000 = (erytrocyternas volym)

Vad innebär MCH?
Mean Cell Hemoglobin
Hb/EPK = (genomsnittlig massa hemoglobin i analyserade erytrocyter)

På vilka två sätt kan vi della in anemier?
MCH - Hb per cell – ger olika färgsättning
MCV - baserat på storlek hos erytrocyterna
När kan vi se små erytrocyter?
Järnbrist, thalassemi
När kan vi se lågt MCV och lågt MCH?
Järnbrist
När kan vi se högt MCV?
Vad kallas det med ett annat ord?
B12-brist och folatbrist
Makrocytär
Vad kallas en neutrofil med många kärnor där vi också kan se ett högt MCV?
Hypersegmenterad neutrofil granulocyt

Vad kallar du en erytrocyt med dessa värden?
MCV - EVF/EPK x 1000 = (erytrocyternas volym)
MCH - Hb/EPK = (genomsnittlig massa hemoglobin i analyserade erytrocyter)
Vad kallar du en erytrocyt med dessa värden?
Mikrocytär hypokrom
Vad kan tyda på en sickelcell-anemi?
Sickleceller (nymånar)
Hypersegmenterade neutrofil granulocyt

Vad kan ökad mängd reticulocyter i blodet tyda på?
ex hyperproliferation och hemolys
Beskriv kortfattat B12-folatcykeln och varför är dessa ämnen viktiga?

Varför tar du provet homocystein på patienten?
Vad kan den säga och hur bör vi gå vidare?
Varför berättar högt MMA att vi har brist på B12?
Vad visar bilden?

Vad visar bilden?

Kalle 71årKallekommer till vårdcentralen.Hanberättaratthanharkäntsigtrött ochdeppigdesenastemånaderna.Kalles fruhar påpekatatt hanharbörjat blilite glömsk. Hanuppleveratt det stickerihänder ochfötter och iblandkännsdet somatthan”gårpåkuddar”. Hanhar ocksåmärktattdet sviderimunnennärhandrickersitt morgonkaffe.Kalleärfrisk förövrigt. Han äter inga mediciner och drickerendastalkohol tilljul ochmidsommar.När man undersökerKalle hittar man nedsattvibrationssinne påbägge fötterna. Han harmunvinkelragaderochenrödtunga. Inget annat avvikandehittas istatus.Man beställer ettantalprover.Medan du väntar på svar på proverna tittar du på ett blodutstryk från Kalle.
Vad vill du kalla det du ser och vad beror det på?

Kallehar enmegaloblastisk anemi pågrund avB12-brist. B12 krävs för DNA-syntesen. Därför sker en mognadshämning i förstadierna och erytrocyterna hinner växa för mycket i storlek innan det finns tillräckligt med kärnmaterial för endelning
Stina23årPåvårdcentralenträffar duStinasomserliteblek ochhängigut.Honberättaratt honnästanalltidkännersigtrött ochattdetoftasvartnar förögonennärhonhastigt ställersigupp.Stinaflyttadehemifrån för ettårsedan.Honharvaritvegetarian sedantonårenochhonerkänner att detärsisådärmedmatlagningen,”det ärsåtråkigtatt laga matbara tillsigsjälv”berättarhon. Stinaärfrisksedantidigare.Honharintesett blod iavföringenochhennesavföringsvanor är normala. Hon äteringamediciner,inte ensp-piller,ochingakosttillskott. Närdufrågar särskilt om p-pillernämner Stina att hon har funderat på att börja med p-piller, inte för att hon har någon pojkvän förnärvarande, utan för att hon har hört att man kan få mindre och mer regelbundna blödningar vid menstruationer när man äter p-piller. Du tar lite prover på Stina.
Vad ser du och vad tror du är grunden till problemet?
Stina har en hypokrom mikrocytär anemi på grund av järnbrist.
Vegetarianen Stina som har rikliga menstrationer har en hypokrom mikrocytär anemi till följd av järnbrist, hur vill du behandla?
Flera riskfaktorer för järnbrist, hon har både rikliga menstruationer och är vegetarian. Du sätter in Stina på järntillskott, Duroferon®, och rekommenderar henne att gå till kvinnohälsan för att diskutera insättning av p-piller.